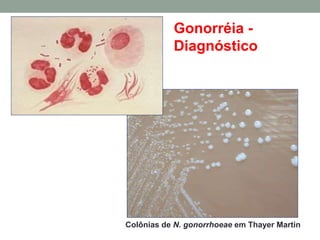
Colônias de N. gonorrhoeae em Thayer Martin
Gonorréia -
Diagnóstico

O documento discute doenças sexualmente transmissíveis, incluindo suas principais causas bacterianas e virais, sintomas, diagnóstico e epidemiologia. Aborda especificamente a sífilis, gonorréia, distribuição geográfica, complicações e importância do diagnóstico precoce.